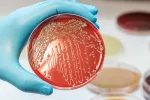
Bacteria E. coli en el laboratorio

La razón por la que no debes comer la masa de las galletas cruda

La harina también es un vehículo de patógenos que puede infectarte de E. coli.
01/12/2017
Se acercan las navidades, una época en la que la cocina tiene más trabajo que nunca, ya que en estas fechas es muy típico preparar en casa galletas, magdalenas, tortitas, y repostería en general, que se añaden a los menús destinados a celebrar los días más señalados; pero, ojo, más vale que detengas ese impulso que tantas veces nos sobreviene de probar cualquier masa elaborada con harina antes de cocinarla, pues podrías acabar en el hospital infectado de Escherichia Coli (E. Coli).
Así lo ha alertado un estudio publicado en la revista The New England Journal of Medicine, que se centra en un brote de E. Coli que se produjo en 2016 como consecuencia del consumo de harina sin cocinar. Durante el mismo se registraron 63 casos de infección en 24 estados diferentes de Estados Unidos, y 17 de las personas afectadas tuvieron que ser hospitalizadas, sufriendo una de ellas un fallo renal, si bien finalmente todas ellas se recuperaron.
Los ‘helados’ de masa de galleta y las masas crudas refrigeradas no suponen un riesgo para la salud, pues se pasteurizan y tratan térmicamente
Aunque el alimento más propenso a tener E. Coli es la carne picada, pues la bacteria suele habitar en ambientes húmedos, la harina también podría ser un vehículo de patógenos, a pesar de tener poca humedad, explica Samuel J. Crowe, epidemiólogo autor principal de la investigación. Sin embargo, no hay que preocuparse, dicen, por los ‘helados’ elaborados a base de masa de galleta (Cookie Dough) tan de moda en los últimos tiempos, ni por las masas refrigeradas, pues éstas pasan por un proceso de pasteurización y se tratan de manera térmica.

Síntomas de la infección por E. Coli
Una de las características de la intoxicación alimentaria por E. Coli es que puede aparecer incluso diez días después de ingerir el alimento contaminado, por lo que muchas veces no se sabe a ciencia cierta qué provocó la infección. Entre los síntomas que denotan la presencia de esta bacteria en el organismo están los vómitos, la diarrea, la fiebre, y los calambres estomacales.
Todos ellos suelen remitir después de una semana; sin embargo, en algunos casos se puede complicar provocando el síndrome urémico hemolítico, que paraliza la función de los riñones, y que puede ser un peligro para la vida y causar daños irreparables en estos órganos. Los investigadores recomiendan lavarse las manos con agua caliente y jabón después de estar en contacto con harina (también después de rebozar alimentos), y no probar nunca los alimentos elaborados con harinas sin cocer o las masas crudas para evitar posibles riesgos.
Actualizado: 4 de mayo de 2023